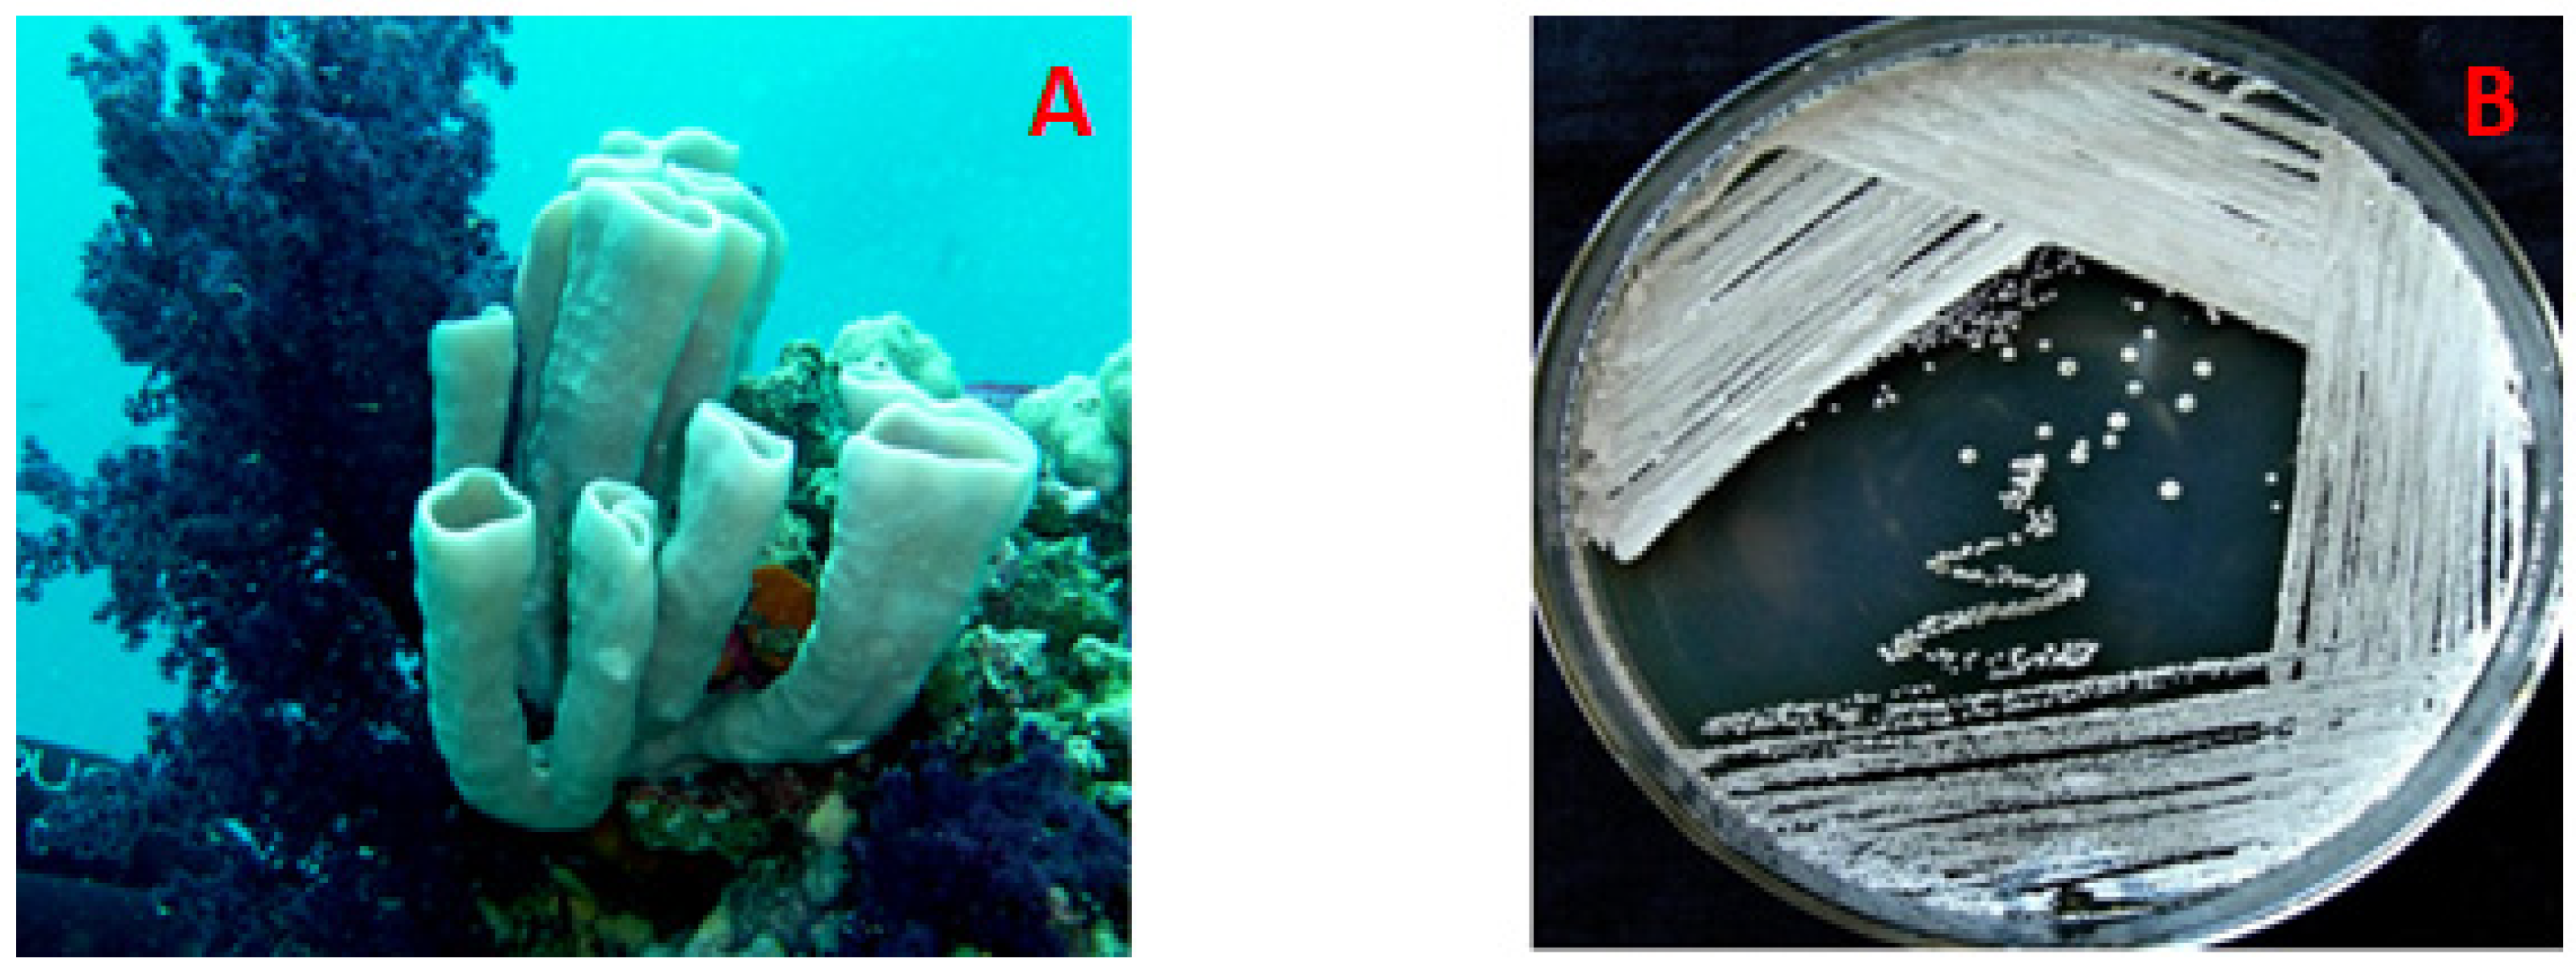
Marinedrugs 18 00450 g001 Marinedrugs 18 00450 g001

Antimicrobial Chlorinated 3-Phenylpropanoic Acid Derivatives from the Red Sea Marine Actinomycete Streptomyces coelicolor LY001
Abstract
1. Introduction
2. Results and Discussion
2.1. Isolation of the Actinomycete, Streptomyces coelicolor LY001
2.2. Structure Elucidation of the Compounds
3. Materials and Methods
3.1. General Experimental Procedures
3.2. The Host Organism, C. siphonella
3.3. Isolation of the Actinomycete Streptomyces coelicolor LY001
3.4. Characterization of the Actinomycete, Streptomyces coelicolor
3.5. Large-Scale Culture of Streptomyces coelicolor
3.6. Purification of 1–7
Spectral Data of 1–7
3.7. Antimicrobial Evaluation of Compounds 1–7
3.7.1. Disc Diffusion Assay
3.7.2. Determination of the MIC of 1–7
4. Conclusions
Supplementary Materials
Author Contributions
Funding
Acknowledgments
Conflicts of Interest
References
- Faulkner, D.J.; Harper, K.K.; Haygood, M.G.; Salomon, C.E.; Schmidt, E.W. Symbiotic bacteria in sponges: Sources of bioactive substances. In Drugs from the Sea; Fusetani, N., Ed.; Karger: Basel, Switzerland, 2000; pp. 107–119. [Google Scholar]
- Tsukimoto, M.; Nagaoka, M.; Shishido, Y.; Fujimoto, J.; Nishisaka, F.; Matsumoto, S.; Haruari, E.; Imada, C.; Matsuzaki, T. Bacterial production of the tunicate-derived antitumor cyclic depsipeptide didemnin B. J. Nat. Prod. 2011, 74, 2329–2331. [Google Scholar] [CrossRef]
- Brinkmann, C.M.; Marker, A.; Kurtböke, D.I. An Overview on Marine sponge-symbiotic bacteria as unexhausted sources for natural product discovery. Diversity 2017, 9, 40. [Google Scholar] [CrossRef]
- Carroll, A.R.; Copp, B.R.; Davis, R.A.; Keyzers, R.A.; Prinsep, M.R. Marine natural products. Nat. Prod. Rep. 2020, 37, 175–223. [Google Scholar] [CrossRef]
- Berdy, J. Bioactive microbial metabolites. J. Antibiot. Tokyo 2005, 58, 1–26. [Google Scholar] [CrossRef]
- Newman, D.J.; Cragg, G.M.; Snader, K.M. Natural products as sources of new drugs over the period 1981–2002. J. Nat. Prod. 2003, 66, 1022–1037. [Google Scholar] [CrossRef]
- Jiménez-Esquilín, A.E.; Roane, E.T.M. Antifungal activities of actinomycete strains associated with high-altitude sagebrush rhizosphere. J. Ind. Microbiol. Biotechnol. 2005, 32, 378–381. [Google Scholar] [CrossRef]
- Olanrewaju, O.S.; Babalola, O.O. Streptomyces: Implications and interactions in plant growth promotion. Appl. Microbiol. Biotechnol. 2019, 103, 1179–1188. [Google Scholar] [CrossRef]
- Ramesh, S.; Rajesh, M.; Mathivanan, N. Characterization of a thermostable alkaline protease produced by marine Streptomyces fungicidicus MML1614. Bioprocess. Biosyst. Eng. 2009, 32, 791–800. [Google Scholar] [CrossRef]
- Prabavathy, V.R.; Mathivanan, N.; Murugesan, K. Control of blast and sheath blight diseases of rice using antifungal metabolites produced by Streptomyces sp. PM5. Biol. Control 2006, 39, 313–319. [Google Scholar] [CrossRef]
- Prapagdee, B.; Kuekulvong, C.; Mongkolsuk, S. Antifungal potential of extracellular metabolites produced by Streptomyces hygroscopicus against phytopathogenic fungi. Int. J. Biol. Sci. 2008, 4, 330–337. [Google Scholar] [CrossRef]
- Lam, K.S. Discovery of novel metabolites from marine actinomycetes. Curr. Opin. Microbiol. 2006, 9, 245–251. [Google Scholar] [CrossRef] [PubMed]
- Hong, K.; Gao, A.H.; Xie, Q.Y.; Gao, H.; Zhuang, L.; Lin, H.P.; Yu, H.P.; Li, J.; Yao, X.S.; Goodfellow, M.; et al. Actinomycetes for marine drug discovery isolated from mangrove soils and plants in China. Mar. Drugs 2009, 7, 24–44. [Google Scholar] [CrossRef] [PubMed]
- Pimentel-Elardo, S.M.; Kozytska, S.; Bugni, T.S.; Ireland, C.M.; Moll, H.; Hentschel, U. Antiparasitic compounds from Streptomyces sp. strains isolated from Mediterranean sponges. Mar. Drugs 2010, 8, 373–380. [Google Scholar] [CrossRef] [PubMed]
- Renner, M.K.; Shen, Y.C.; Cheng, X.C.; Jensen, P.R.; Frankmoelle, W.; Kauffman, C.A.; Fenical, W.; Lobkovsky, E.; Clardy, J. Cyclomarins A-C, new anti-inflammatory cyclic peptides produced by a marine bacterium (Streptomyces sp.). J. Am. Chem. Soc. 1999, 121, 11273–11276. [Google Scholar] [CrossRef]
- Xu, Y.; He, H.; Schulz, S.; Liu, X.; Fusetani, N.; Xiong, H.; Xiao, X.; Qian, P.Y. Potent antifouling compounds produced by marine Streptomyces. Bioresour. Technol. 2010, 101, 1331–1336. [Google Scholar] [CrossRef]
- Sacramento, D.R.; Coelho, R.R.R.; Wigg, M.D.; Linhares, L.F.T.L.; Santos, M.G.M.; Semedo, L.T.A.S.; da Silva, A.J.R. Antimicrobial and antiviral activities of an actinomycete (Streptomyces sp.) isolated from a Brazilian tropical forest soil. World J. Microbiol. Biotechnol. 2004, 20, 225–229. [Google Scholar] [CrossRef]
- Rahman, H.; Austin, B.; Mitchell, W.J.; Morris, P.C.; Jamieson, D.J.; Adams, D.R.; Spragg, A.M.; Schweizer, M. Novel anti-infective compounds from marine bacteria. Mar. Drugs 2010, 8, 498–518. [Google Scholar] [CrossRef]
- Williams, S.T.; Goodfellow, M.; Alderson, G.; Wellington, E.M.H.; Sneath, P.H.A.; Sackin, M.J. A probability matrix for identification of some Streptomyces. J. Gen. Microbiol. 1983, 129, 1815–1830. [Google Scholar]
- Tamehiro, N.; Hosaka, T.; Xu, J.; Hu, H.; Otake, N.; Ochi, K. Innovative approach for improvement of an antibiotic–overproducing industrial strain of Streptomyces albus. Appl. Environ. Microbiol. 2003, 69, 6412–6417. [Google Scholar] [CrossRef][Green Version]
- Higginbotham, S.J.; Murphy, C.D. Identification and characterisation of a Streptomyces sp. isolate exhibiting activity against methicillin-resistant Staphylococcus aureus. Microbiol. Res. 2010, 165, 82–86. [Google Scholar] [CrossRef]
- Sousa, C.S.; Soares, A.C.F.; Garrido, M.S. Characterization of streptomycetes with potential to promote plant growth and biocontrol. Sci. Agric. Piracicaba Braz. 2008, 65, 50–55. [Google Scholar] [CrossRef]
- Atta, H.M. Production of vitamin B12 by Streptomyces fulvissimus. Egypt. J. Biomed. Sci. 2007, 23, 166–184. [Google Scholar]
- Cal, S.; Aparicio, J.F.; De Los Reyes-Gavilan, C.G.; Nicieza, J.; Sanchez, A. A novel exocytoplasmic endonuclease from Streptomyces antibioticus. J. Biochem. 1995, 306, 93–100. [Google Scholar] [CrossRef]
- Brunakova, Z.; Godnay, A.; Timko, J. An extracellular endodeoxyribonuclease from Sterptomyces aureofaciens. Biochim. Biophys. Acta 2004, 1721, 116–123. [Google Scholar] [CrossRef]
- Ramesh, S.; Mathivanan, N. Screening of marine actinomycetes isolated from the Bay of Bengal, India for antimicrobial activity and industrial enzymes. World J. Microbiol. Biotechnol. 2009, 25, 2103–2111. [Google Scholar] [CrossRef]
- Nicieza, R.G.; Huergo, J.; Connolly, B.A.; Sanchex, J. Purification, characterization and role of nucleases and serine proteases in Streptomyces differentiation. J. Biol. Chem. 1999, 274, 20366–20375. [Google Scholar] [CrossRef]
- Magarvey, N.A.; Keller, J.M.; Bernan, V.; Dworkin, M.; Sherman, D.H. Isolation and characterization of novel marine-derived actinomycete taxa rich in bioactive metabolites. Appl. Environ. Microbiol. 2004, 70, 7520–7529. [Google Scholar] [CrossRef]
- Fenical, W.; Jensen, P.R. Developing a new resource for drug discovery: Marine actinomycete bacteria. Nat. Chem. Biol. 2006, 2, 666–673. [Google Scholar] [CrossRef]
- Jensen, P.R.; Williams, P.G.; Oh, D.C.; Zeigler, L.; Fenical, W. Species-specific secondary metabolite production in marine actinomycetes of the genus Salinispora. Appl. Environ. Microbiol. 2007, 73, 1146–1152. [Google Scholar] [CrossRef]
- Zazopoulos, E.; Huang, K.; Staffa, A.; Liu, W.; Bachmann, B.O.; Nonaka, K.; Ahlert, J.; Thorson, J.S.; Shen, B.; Farnet, C.M. A genomics-guided approach for discovering and expressing cryptic metabolic pathways. Nat. Biotechnol. 2003, 21, 187–190. [Google Scholar] [CrossRef]
- McAlpine, J.B.; Bachmann, B.O.; Piraee, M.; Tremblay, S.; Alarco, A.M.; Zazopoulos, E.; Farnet, C.M. Microbial genomics as a guide to drug discovery and structural elucidation: ECO-02301, a novel antifungal agent, as an example. J. Nat. Prod. 2005, 68, 493–496. [Google Scholar] [CrossRef] [PubMed]
- Udwary, D.W.; Zeigler, L.; Asolkar, R.N.; Singan, V.; Lapidus, A.; Fenical, W.; Jensen, P.R.; Moore, B.S. Genome sequencing reveals complex secondary metabolome in the marine actinomycete Salinispora tropica. Proc. Natl. Acad. Sci. USA 2007, 104, 10376–10381. [Google Scholar] [CrossRef] [PubMed]
- Sakata, T.; Winzeler, E.A. Genomics, systems biology and drug development for infectious diseases. Mol. Biosyst. 2007, 3, 841–848. [Google Scholar] [CrossRef] [PubMed]
- Shaala, L.A.; Youssef, D.T.A.; Badr, J.M.; Harakeh, S.M. Bioactive 2(1H)-pyrazinones and diketopiperazine alkaloids from a tunicate-derived actinomycete Streptomyces sp. Molecules 2016, 21, 1116. [Google Scholar] [CrossRef] [PubMed]
- Shaala, L.A.; Youssef, D.T.A.; Badr, J.M.; Harakeh, S.M.; Genta-Jouve, G. Bioactive diketopiperazines and nucleoside derivatives from a sponge-derived Streptomyces species. Mar. Drugs 2019, 17, 584. [Google Scholar] [CrossRef] [PubMed]
- Narayana, K.J.P.; Prabhakar, P.; Vijayalakshm, M.; Venkateswarlu, Y.; Krishna, P.S.J. Biological activity of phenylpropionic acid isolated from a terrestrial Streptomycetes. Pol. J. Microbiol. 2007, 56, 191–197. [Google Scholar] [PubMed]
- Adamczeski, M.; Quinoa, E.; Crews, P. Novel sponge-derived amino acids. 5. Structures, stereochemistry, and synthesis of several new heterocycles. J. Am. Chem. Soc. 1989, 111, 647–654. [Google Scholar] [CrossRef]
- Li, X.-Y.; Wang, Y.-H.; Yang, J.; Cui, W.-Y.; He, P.-J.; Munir, S.; He, P.-F.; Wu, Y.-X.; He, Y.-Q. Acaricidal activity of cyclodipeptides from Bacillus amyloliquefaciens W1 against Tetranychus urticae. J. Agric. Food Chem. 2018, 66, 10163–10168. [Google Scholar] [CrossRef]
- Shigemori, H.; Tenma, M.; Shimazaki, K.; Kobayashi, J. Three new metabolites from the marine yeast Aureobasidium pullulans. J. Nat. Prod. 1998, 61, 696–698. [Google Scholar] [CrossRef]
- De Rosa, S.; Mitova, M.; Tommonaro, G. Marine bacteria associated with sponge as source of cyclic peptides. Biomol. Eng. 2003, 20, 311–316. [Google Scholar] [CrossRef]
- Restrepo, M.P.; Jaramillo, E.G.; Martínez, A.M.; Arango, A.M.; Restrepo, S.R. Anti-parasite and cytotoxic activities of chloro and bromo L-tyrosine derivatives. J. Braz. Chem. Soc. 2018, 29, 2569–2579. [Google Scholar] [CrossRef]
- Barros, J.; Serrani-Yarce, J.C.; Chen, F.; Baxter, D.; Venables, B.J.; Dixon, R.A. Role of bifunctional ammonia-lyase in grass cell wall biosynthesis. Nat. Plants 2016, 2, 16050. [Google Scholar] [CrossRef] [PubMed]
- Vogt, T. Phenylpropanoid biosynthesis. Mol. Plant 2010, 3, 2–20. [Google Scholar] [CrossRef] [PubMed]
- Jain, S.; Laphookhieo, S.; Shi, Z.; Fu, L.; Akiyama, S.; Chen, Z.; Youssef, D.T.A.; van Soest, R.W.M.; El Sayed, K.A. Reversal of P-glycoprotein-mediated multidrug resistance by sipholane triterpenoids. J. Nat. Prod. 2007, 70, 928–931. [Google Scholar] [CrossRef]
- Youssef, D.T.A.; Ibrahim, A.K.; Khalifa, S.I.; Mesbah, M.K.; Mayer, A.M.S.; van Soest, R.W.M. New anti-inflammatory sterols from the Red Sea sponges Scalarispongia aqabaensis and Callyspongia siphonella. Nat. Prod. Commun. 2010, 5, 27–31. [Google Scholar]
- Küster, E. Outline of a comparative study of criteria used in characterization of the actinomycetes. Int. Bull. Bacteriol. Nomencl. Taxon. 1959, 9, 97–104. [Google Scholar] [CrossRef]
- Acar, J.F. The disc susceptibility test. In Antibiotics in Laboratory Medicine; Lorian, V., Ed.; Williams and Wilkins: Baltimore, MD, USA, 1980; pp. 24–54. [Google Scholar]
- Kiehlbauch, J.A.; Hannett, G.E.; Salfinger, M.; Archinal, W.; Monserrat, C.; Carlyn, C. Use of the National Committee for Clinical Laboratory Standards Guidelines for Disk Diffusion Susceptibility Testing in New York State Laboratories. J. Clin. Microbiol. 2000, 38, 3341–3348. [Google Scholar] [CrossRef]
- Shaala, L.A.; Khalifa, S.I.; Mesbah, M.K.; van Soest, R.W.M.; Youssef, D.T.A. Subereaphenol A, a new cytotoxic and antimicrobial dibrominated phenol from the Red Sea sponge Suberea mollis. Nat. Prod. Commun. 2008, 3, 219–222. [Google Scholar] [CrossRef]
- CLSI, Clinical and Laboratory Standards Institute. Performance Standards for Antimicrobial Disk Susceptibility Tests, 9th ed.; CLSI Documents M07-A9; West Valley Road: Wayne, PA, USA, 2007. [Google Scholar]

| Position | 1 | 2 | 3 | |||
|---|---|---|---|---|---|---|
| δC (mult.) a | δH (mult., J in Hz) | δC (mult.) a | δH (mult., J in Hz) | δC (mult.) a | δH (mult., J in Hz) | |
| 1 | 133.6, qC | 133.8, qC | 133.5, qC | |||
| 2 | 128.1, CH | 7.12 (s) | 128.1, CH | 7.10 (s) | 128.6, CH | 7.17 (d, 2.5) |
| 3 | 122.1, qC | 121.0, qC | 120.8, qC | |||
| 4 | 146.9, qC | 146.6, qC | 151.7, qC | |||
| 5 | 122.1, qC | 121.0, qC | 116.1, CH | 6.93 (d, 8.5) | ||
| 6 | 128.1, CH | 7.12 (s) | 128.1, CH | 7.10 (s) | 128.4, CH | 7.02 (dd, 8.5, 2.5) |
| 7 | 29.3, CH2 | 2.86 (t, 7.6) | 29.8, CH2 | 2.84 (t, 7.6) | 29.5, CH2 | 2.86 (t, 7.6) |
| 8 | 34.5, CH2 | 2.64 (t, 7.6) | 35.3, CH2 | 2.59 (t, 7.6) | 34.8, CH2 | 2.65 (t, 7.6) |
| 9 | 173.8, qC | 173.3, qC | 173.9, qC | |||
| 10 | 51.9, CH3 | 3.67 (s) | ||||
| Position | 6 (1H at 600 MHz, 13C at 150 MHz) | 7 (1H at 850 MHz, 13C at 213 Hz) | ||
|---|---|---|---|---|
| δC (mult.) a | δH (mult., J in Hz) | δC (mult.) a | δH (mult., J in Hz) | |
| 2 | 165.0, qC | 165.2, qC | ||
| 3 | 56.1, CH | 4.33 (dd, 10.8, 3.0) | 59.1, CH | 4.23 (tt, 4.2) |
| 4 (NH) | 5.60 (brs) | 5.80 (brs) | ||
| 5 | 169.5, qC | 168.4, qC | ||
| 6 | 57.3, CH | 4.46 (dd, 10.8, 6.0) | 55.8, CH | 3.17 (t, 8.5) |
| 7a | 37.8, CH2 | 2.37 (dd, 13.8, 6.0) | 38.0, CH2 | 2.37 (ddd,13.7, 8.5, 5.1) |
| 7b | 2.06 (ddd, 13.8, 11.4, 4.2) | 2.20 (m) | ||
| 8 | 68.4, CH | 4.60 (t, 4.2) | 68.1, CH | 4.40 (quin, 4.0) |
| 9a | 54.4, CH2 | 3.80 (dd, 13.2, 4.2) | 53.4, CH2 | 3.82 (dd, 12.7, 2.5) |
| 9b | 3.58 (d, 13.2) | 3.35 (dd, 12.7, 5.1) | ||
| 10a | 36.6, CH2 | 3.63 (dd, 14.5, 4.2) | 40.8, CH2 | 3.13 (dd, 14.0, 6.8) |
| 10b | 2.77 (dd, 15.5, 10.8) | 3.10 (dd, 14.0, 4.2) | ||
| 11 | 135.7, qC | 135.2, qC | ||
| 12 | 129.0, CH | 7.22 (d, 7.5) | 129.7, CH | 7.21 (d, 7.3) |
| 13 | 129.3, CH | 7.36 (t, 7.5) | 128.9, CH | 7.31 (t, 7.3) |
| 14 | 127.6, CH | 7.29 (t, 7.5) | 127.6, CH | 7.30 (t, 7.3) |
| 15 | 129.3, CH | 7.36 (t, 7.5) | 128.9, CH | 7.31 (t, 7.3) |
| 16 | 129.0, CH | 7.22 (d, 7.5) | 129.7, CH | 7.21 (d, 7.3) |
| Compound | E. coli | S. aureus | C. albicans | |||
|---|---|---|---|---|---|---|
| Inhibition Zone (mm) | MIC (µg/mL) | Inhibition Zone (mm) | MIC (µg/mL) | Inhibition Zone (mm) | MIC (µg/mL) | |
| 1 | 23 | 16 | 17 | 32 | 9 | 125 |
| 2 | 20 | 32 | 12 | 64 | 7 | 250 |
| 3 | 18 | 32 | 15 | 32 | 7 | 250 |
| 4 | 15 | 64 | 11 | 125 | 6 | 250 |
| 5 | NT | NT | NT | NT | NT | NT |
| 6 | 7 | 250 | 9 | 250 | 12 | 32 |
| 7 | 11 | 125 | 7 | 250 | 14 | 32 |
| Ciprofloxacin a | 30 | 0.25 | 22 | 0.5 | NT | NT |
| Ketoconazole b | NT | NT | NT | NT | 30 | 0.5 |
© 2020 by the authors. Licensee MDPI, Basel, Switzerland. This article is an open access article distributed under the terms and conditions of the Creative Commons Attribution (CC BY) license (http://creativecommons.org/licenses/by/4.0/).
Share and Cite
Shaala, L.A.; Youssef, D.T.A.; Alzughaibi, T.A.; Elhady, S.S. Antimicrobial Chlorinated 3-Phenylpropanoic Acid Derivatives from the Red Sea Marine Actinomycete Streptomyces coelicolor LY001. Mar. Drugs 2020, 18, 450. https://doi.org/10.3390/md18090450
Shaala LA, Youssef DTA, Alzughaibi TA, Elhady SS. Antimicrobial Chlorinated 3-Phenylpropanoic Acid Derivatives from the Red Sea Marine Actinomycete Streptomyces coelicolor LY001. Marine Drugs. 2020; 18(9):450. https://doi.org/10.3390/md18090450
Chicago/Turabian StyleShaala, Lamiaa A., Diaa T. A. Youssef, Torki A. Alzughaibi, and Sameh S. Elhady. 2020. "Antimicrobial Chlorinated 3-Phenylpropanoic Acid Derivatives from the Red Sea Marine Actinomycete Streptomyces coelicolor LY001" Marine Drugs 18, no. 9: 450. https://doi.org/10.3390/md18090450
APA StyleShaala, L. A., Youssef, D. T. A., Alzughaibi, T. A., & Elhady, S. S. (2020). Antimicrobial Chlorinated 3-Phenylpropanoic Acid Derivatives from the Red Sea Marine Actinomycete Streptomyces coelicolor LY001. Marine Drugs, 18(9), 450. https://doi.org/10.3390/md18090450

